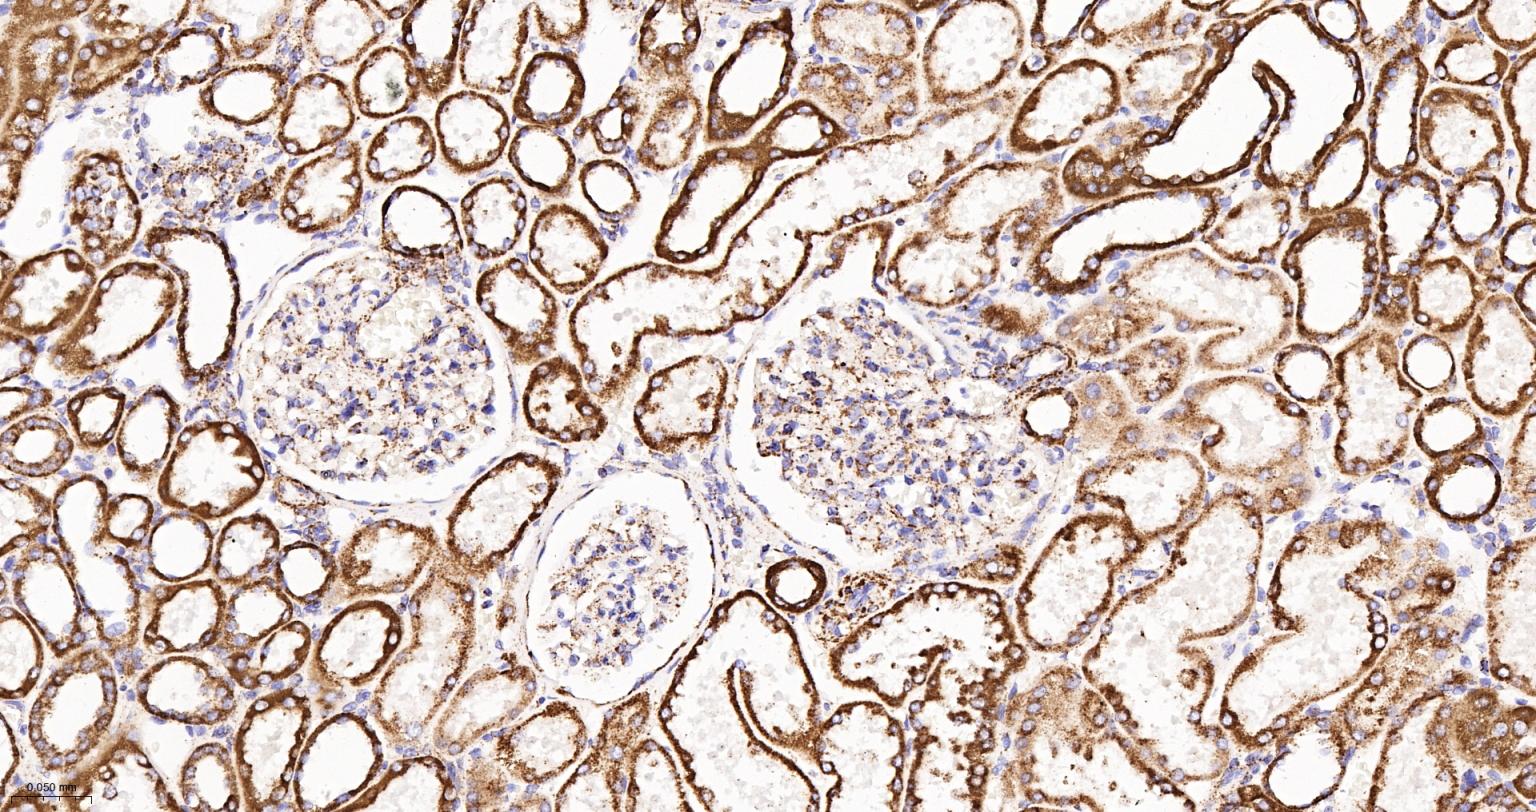
MDH2 Recombinant Rabbit mAb(bs

相关产品推荐更多 >

ZNF804B Rabbit pAb, Cy5 conjugated(bs-16444R-Cy5)-100ul
¥2980
phospho-YES1 (Tyr537) Rabbit pAb, BF750 conjugated(bs-5592R-BF750)-100ul
¥2980
SPINK8 Rabbit pAb, Biotin conjugated(bs-17675R-Bio)-100ul
¥2980
IGSF9 Rabbit pAb, Cy7 conjugated(bs-9199R-Cy7)-100ul
¥2980
beta Actin Recombinant Rabbit mAb, APC-Cy7 conjugated(bsm-63325R-APC-Cy7)-100ul
¥2980
万千商家帮你免费找货
0 人在求购买到急需产品
- 详细信息
- 技术资料
- 应用范围:
产品信息以Bioss网站为准
- 规格:
50ul/100ul/25ul
| 规格: | 50ul | 产品价格: | ¥1400.0 |
|---|---|---|---|
| 规格: | 100ul | 产品价格: | ¥2500.0 |
| 规格: | 25ul | 产品价格: | ¥800.0 |
| 产品编号 | bsm-62699R |
| 英文名称 | MDH2 Recombinant Rabbit mAb |
| 中文名称 | 线粒体苹果酸脱氢酶2重组兔单抗 |
| 英文别名 | M MDH; Malate dehydrogenase. |
| 产品应用 | WB=1:500-2000, IHC-P=1:100-500, IHC-F=1:100-500, IF=1:100-500 Not yet tested in other applications. |
| 交叉反应 | Human, Mouse, Rat |
| 抗体来源 | Rabbit |
| 免疫原 | A synthesized peptide derived from human MDH2 |
| 亚型 | IgG |
| 性状 | Liquid |
| 纯化方法 | affinity purified by Protein A |
| 克隆类型 | Recombinant |
| 理论分子量 | 36 |
| 实际分子量 | 36 |
| 储存液 | 10mM phosphate buffered saline(pH 7.4) with 150mM sodium chloride, 0.05% BSA, 0.02% Proclin300 and 50% glycerol. |
| 研究领域 | Metabolism > Pathways and Processes > Metabolic signaling pathways > Energy transfer pathways > Energy Metabolism Metabolism > Pathways and Processes > Mitochondrial Metabolism > Mitochondrial markers Signal Transduction > Metabolism > Energy Metabolism Signal Transduction > Metabolism > Mitochondrial Tags & Cell Markers > Subcellular Markers > Organelles > Mitochondria |
| 亚基 | Homodimer. |
| 亚细胞定位 | Mitochondrion matrix. |
| 翻译后修饰 | Phosphorylation at Ser-88 appears to control the dimer-monomer transition. |
| 相似性 | Belongs to the LDH/MDH superfamily. MDH type 1 family. |
| 保存条件 | Store at 4℃ for short term. Store at -20℃ for long term. Avoid repeated freeze/thaw cycles. |
| 注意事项 | This product as supplied is intended for research use only, not for use in human, therapeutic or diagnostic applications. |
| 背景资料 | Belongs to the LDH/MDH superfamily. MDH type 1 family. |
| 应用 | 推荐稀释比例 |
| {WB} | {1:500-2000} |
| {IHC-P} | {1:100-500} |
| {IHC-F} | {1:100-500} |
| {IF} | {1:100-500} |

Western blot analysis of K562 cell lysate. Using MDH2 (bsm-62699R) monoclonal antibody at 1:1000 dilution and 4°C overnight incubation. Followed by conjugated secondary antibody incubation at r.t. for 60 min.

Paraformaldehyde-fixed, paraffin embedded Mouse Liver; Antigen retrieval by boiling in sodium citrate buffer (pH6.0) for 15 min; The section was incubated with MDH2 Monoclonal Antibody, Unconjugated (bsm-62699R) at 1:200 overnight at 4°C, followed by conjugation to the bs-0295G-HRP and DAB (C-0010) staining.

Paraformaldehyde-fixed, paraffin embedded Rat Liver; Antigen retrieval by boiling in sodium citrate buffer (pH6.0) for 15 min; The section was incubated with MDH2 Monoclonal Antibody, Unconjugated (bsm-62699R) at 1:200 overnight at 4°C, followed by conjugation to the bs-0295G-HRP and DAB (C-0010) staining.

Paraformaldehyde-fixed, paraffin embedded Human Liver; Antigen retrieval by boiling in sodium citrate buffer (pH6.0) for 15 min; The section was incubated with MDH2 Monoclonal Antibody, Unconjugated (bsm-62699R) at 1:200 overnight at 4°C, followed by conjugation to the bs-0295G-HRP and DAB (C-0010) staining.

Paraformaldehyde-fixed, paraffin embedded Mouse Testicles; Antigen retrieval by boiling in sodium citrate buffer (pH6.0) for 15 min; The section was incubated with MDH2 Monoclonal Antibody, Unconjugated (bsm-62699R) at 1:200 overnight at 4°C, followed by conjugation to the bs-0295G-HRP and DAB (C-0010) staining.

Paraformaldehyde-fixed, paraffin embedded Rat Testicles; Antigen retrieval by boiling in sodium citrate buffer (pH6.0) for 15 min; The section was incubated with MDH2 Monoclonal Antibody, Unconjugated (bsm-62699R) at 1:200 overnight at 4°C, followed by conjugation to the bs-0295G-HRP and DAB (C-0010) staining.

Paraformaldehyde-fixed, paraffin embedded Human Testicles; Antigen retrieval by boiling in sodium citrate buffer (pH6.0) for 15 min; The section was incubated with MDH2 Monoclonal Antibody, Unconjugated (bsm-62699R) at 1:200 overnight at 4°C, followed by conjugation to the bs-0295G-HRP and DAB (C-0010) staining.

Paraformaldehyde-fixed, paraffin embedded Mouse Colon; Antigen retrieval by boiling in sodium citrate buffer (pH6.0) for 15 min; The section was incubated with MDH2 Monoclonal Antibody, Unconjugated (bsm-62699R) at 1:200 overnight at 4°C, followed by conjugation to the bs-0295G-HRP and DAB (C-0010) staining.

Paraformaldehyde-fixed, paraffin embedded Rat Colon; Antigen retrieval by boiling in sodium citrate buffer (pH6.0) for 15 min; The section was incubated with MDH2 Monoclonal Antibody, Unconjugated (bsm-62699R) at 1:200 overnight at 4°C, followed by conjugation to the bs-0295G-HRP and DAB (C-0010) staining.

Paraformaldehyde-fixed, paraffin embedded Human Colon; Antigen retrieval by boiling in sodium citrate buffer (pH6.0) for 15 min; The section was incubated with MDH2 Monoclonal Antibody, Unconjugated (bsm-62699R) at 1:200 overnight at 4°C, followed by conjugation to the bs-0295G-HRP and DAB (C-0010) staining.

Paraformaldehyde-fixed, paraffin embedded Mouse Kidney; Antigen retrieval by boiling in sodium citrate buffer (pH6.0) for 15 min; The section was incubated with MDH2 Monoclonal Antibody, Unconjugated (bsm-62699R) at 1:200 overnight at 4°C, followed by conjugation to the bs-0295G-HRP and DAB (C-0010) staining.

Paraformaldehyde-fixed, paraffin embedded Rat Kidney; Antigen retrieval by boiling in sodium citrate buffer (pH6.0) for 15 min; The section was incubated with MDH2 Monoclonal Antibody, Unconjugated (bsm-62699R) at 1:200 overnight at 4°C, followed by conjugation to the bs-0295G-HRP and DAB (C-0010) staining.
Paraformaldehyde-fixed, paraffin embedded Human Kidney; Antigen retrieval by boiling in sodium citrate buffer (pH6.0) for 15 min; The section was incubated with MDH2 Monoclonal Antibody, Unconjugated (bsm-62699R) at 1:200 overnight at 4°C, followed by conjugation to the bs-0295G-HRP and DAB (C-0010) staining.

Paraformaldehyde-fixed, paraffin embedded Mouse Duodenum; Antigen retrieval by boiling in sodium citrate buffer (pH6.0) for 15 min; The section was incubated with MDH2 Monoclonal Antibody, Unconjugated (bsm-62699R) at 1:200 overnight at 4°C, followed by conjugation to the bs-0295G-HRP and DAB (C-0010) staining.

Paraformaldehyde-fixed, paraffin embedded Rat Duodenum; Antigen retrieval by boiling in sodium citrate buffer (pH6.0) for 15 min; The section was incubated with MDH2 Monoclonal Antibody, Unconjugated (bsm-62699R) at 1:200 overnight at 4°C, followed by conjugation to the bs-0295G-HRP and DAB (C-0010) staining.

Paraformaldehyde-fixed, paraffin embedded Human Duodenum; Antigen retrieval by boiling in sodium citrate buffer (pH6.0) for 15 min; The section was incubated with MDH2 Monoclonal Antibody, Unconjugated (bsm-62699R) at 1:200 overnight at 4°C, followed by conjugation to the bs-0295G-HRP and DAB (C-0010) staining.

Paraformaldehyde-fixed, paraffin embedded Human Breast Cancer; Antigen retrieval by boiling in sodium citrate buffer (pH6.0) for 15 min; The section was incubated with MDH2 Monoclonal Antibody, Unconjugated (bsm-62699R) at 1:200 overnight at 4°C, followed by conjugation to the bs-0295G-HRP and DAB (C-0010) staining.
风险提示:丁香通仅作为第三方平台,为商家信息发布提供平台空间。用户咨询产品时请注意保护个人信息及财产安全,合理判断,谨慎选购商品,商家和用户对交易行为负责。对于医疗器械类产品,请先查证核实企业经营资质和医疗器械产品注册证情况。
 技术资料
技术资料暂无技术资料 索取技术资料
MDH2 Recombinant Rabbit mAb(bsm-62699R)-50ul/100ul/25ul
¥800 - 2500





